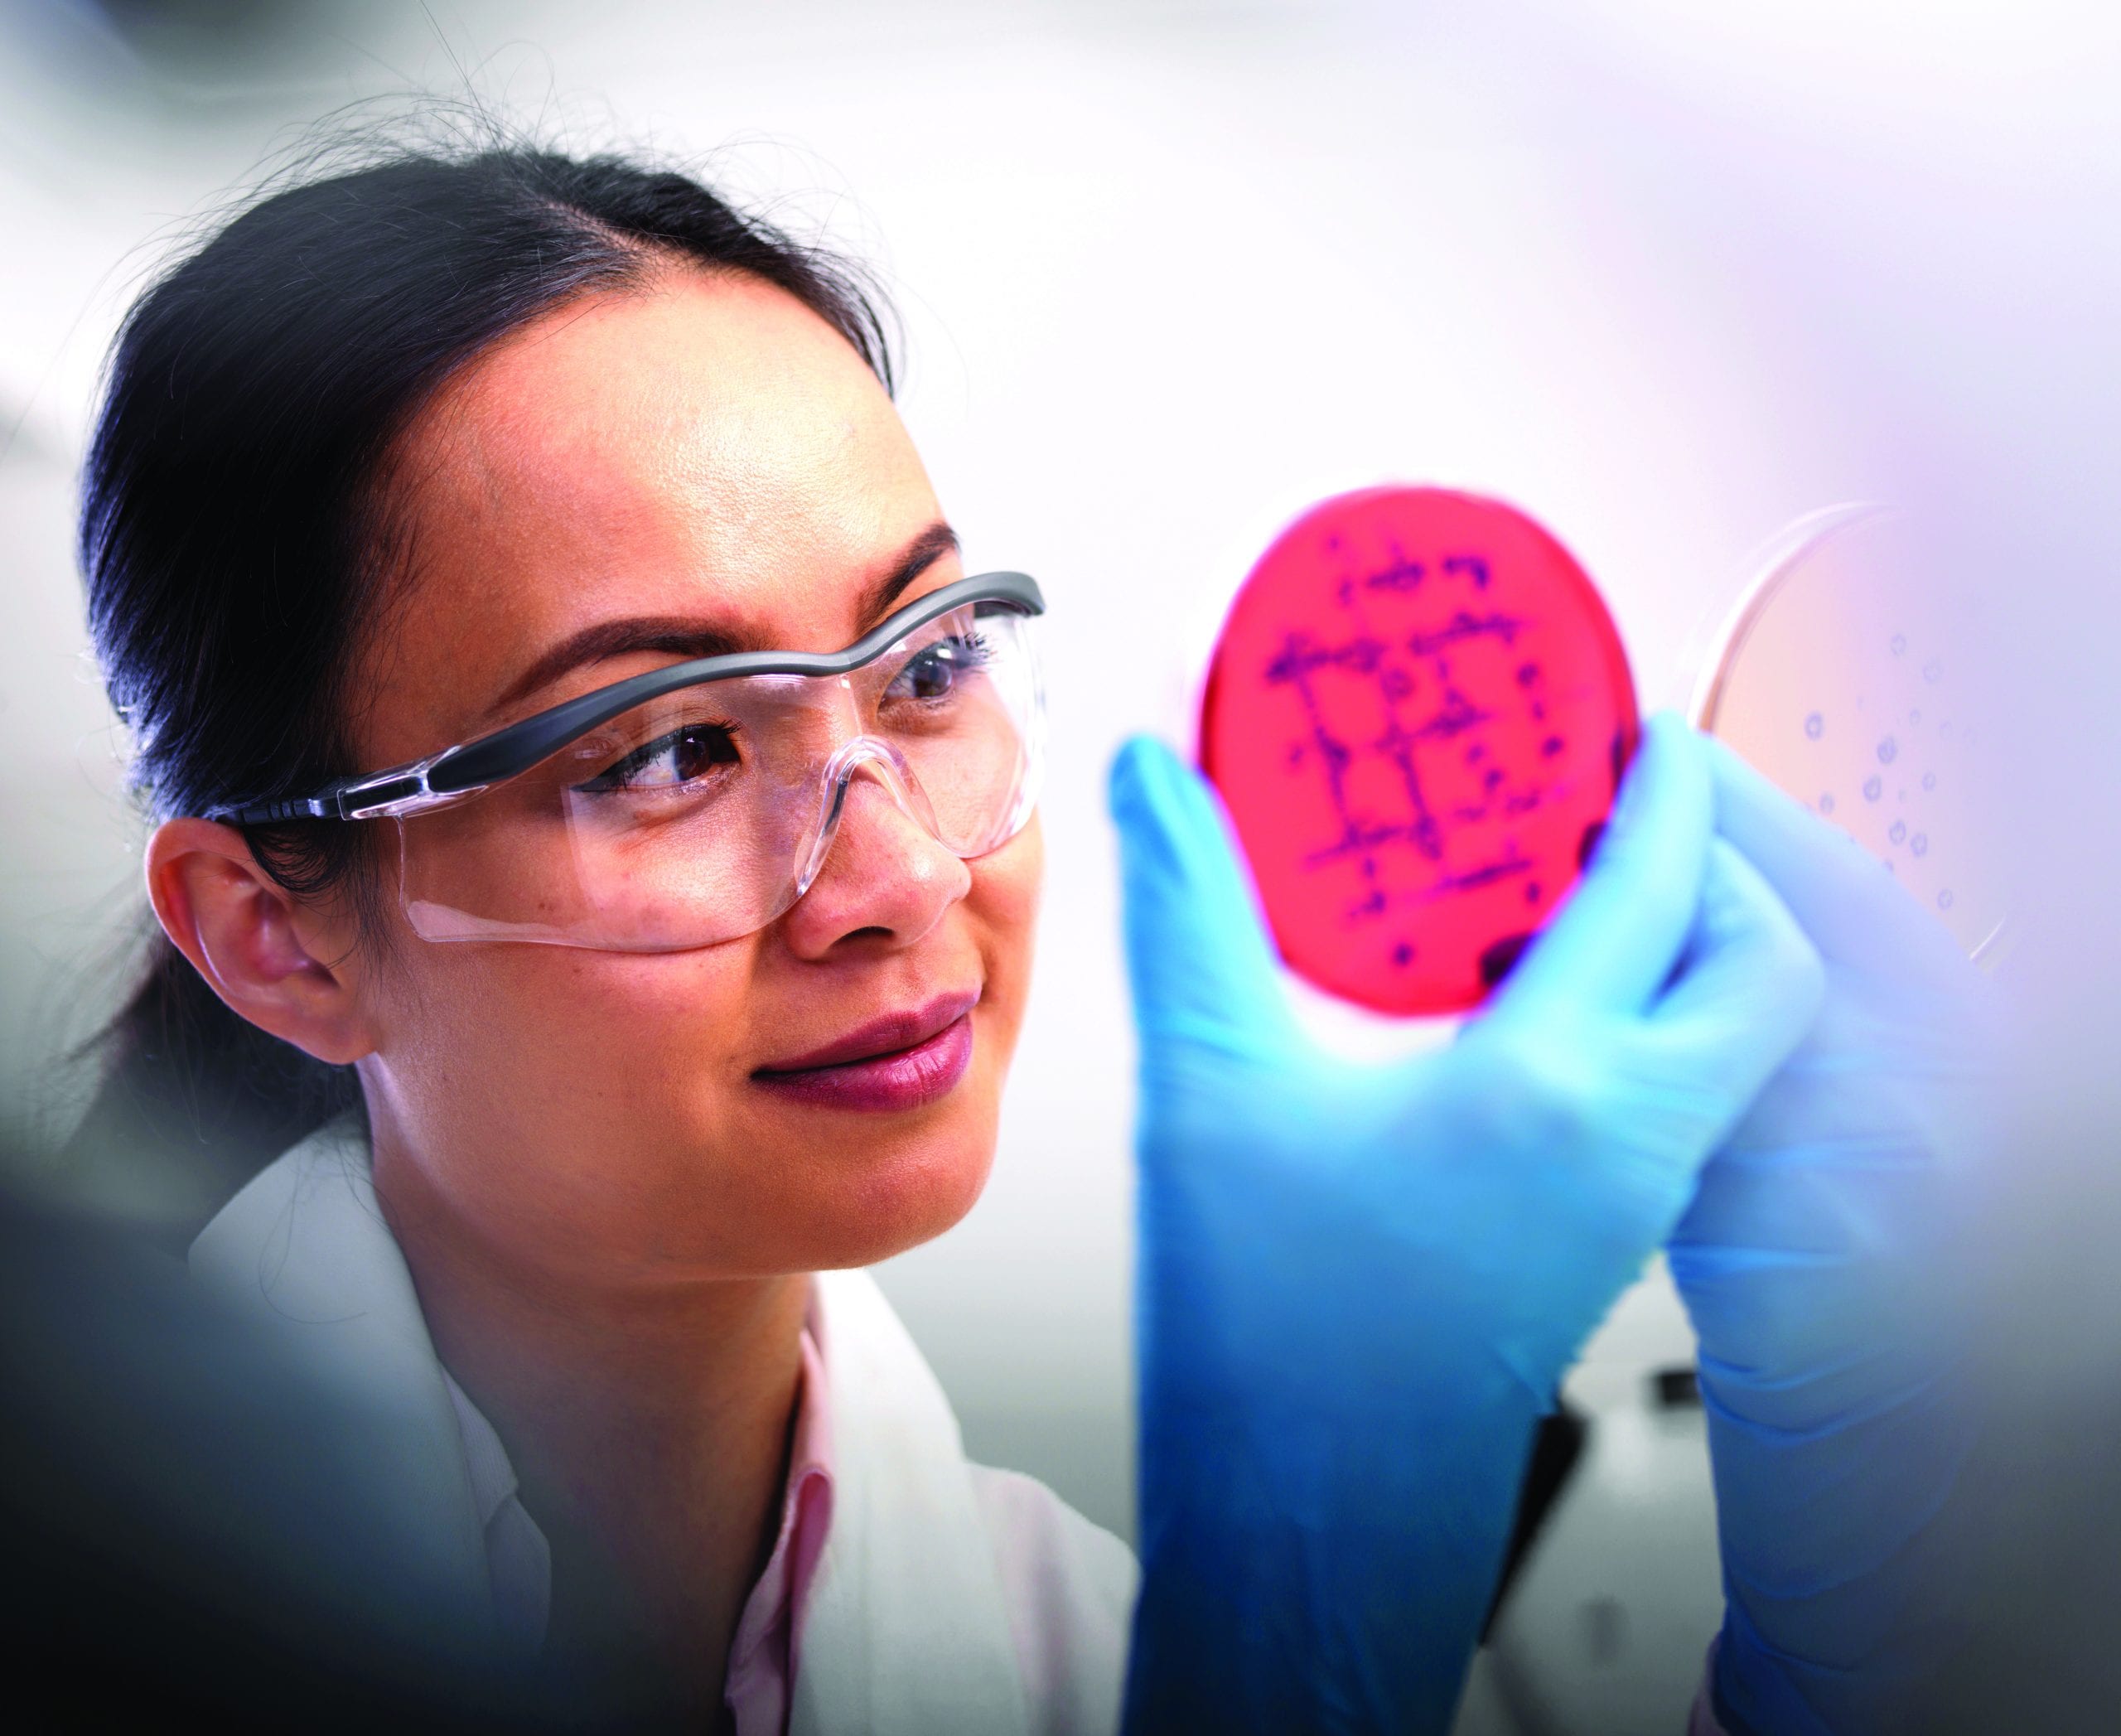
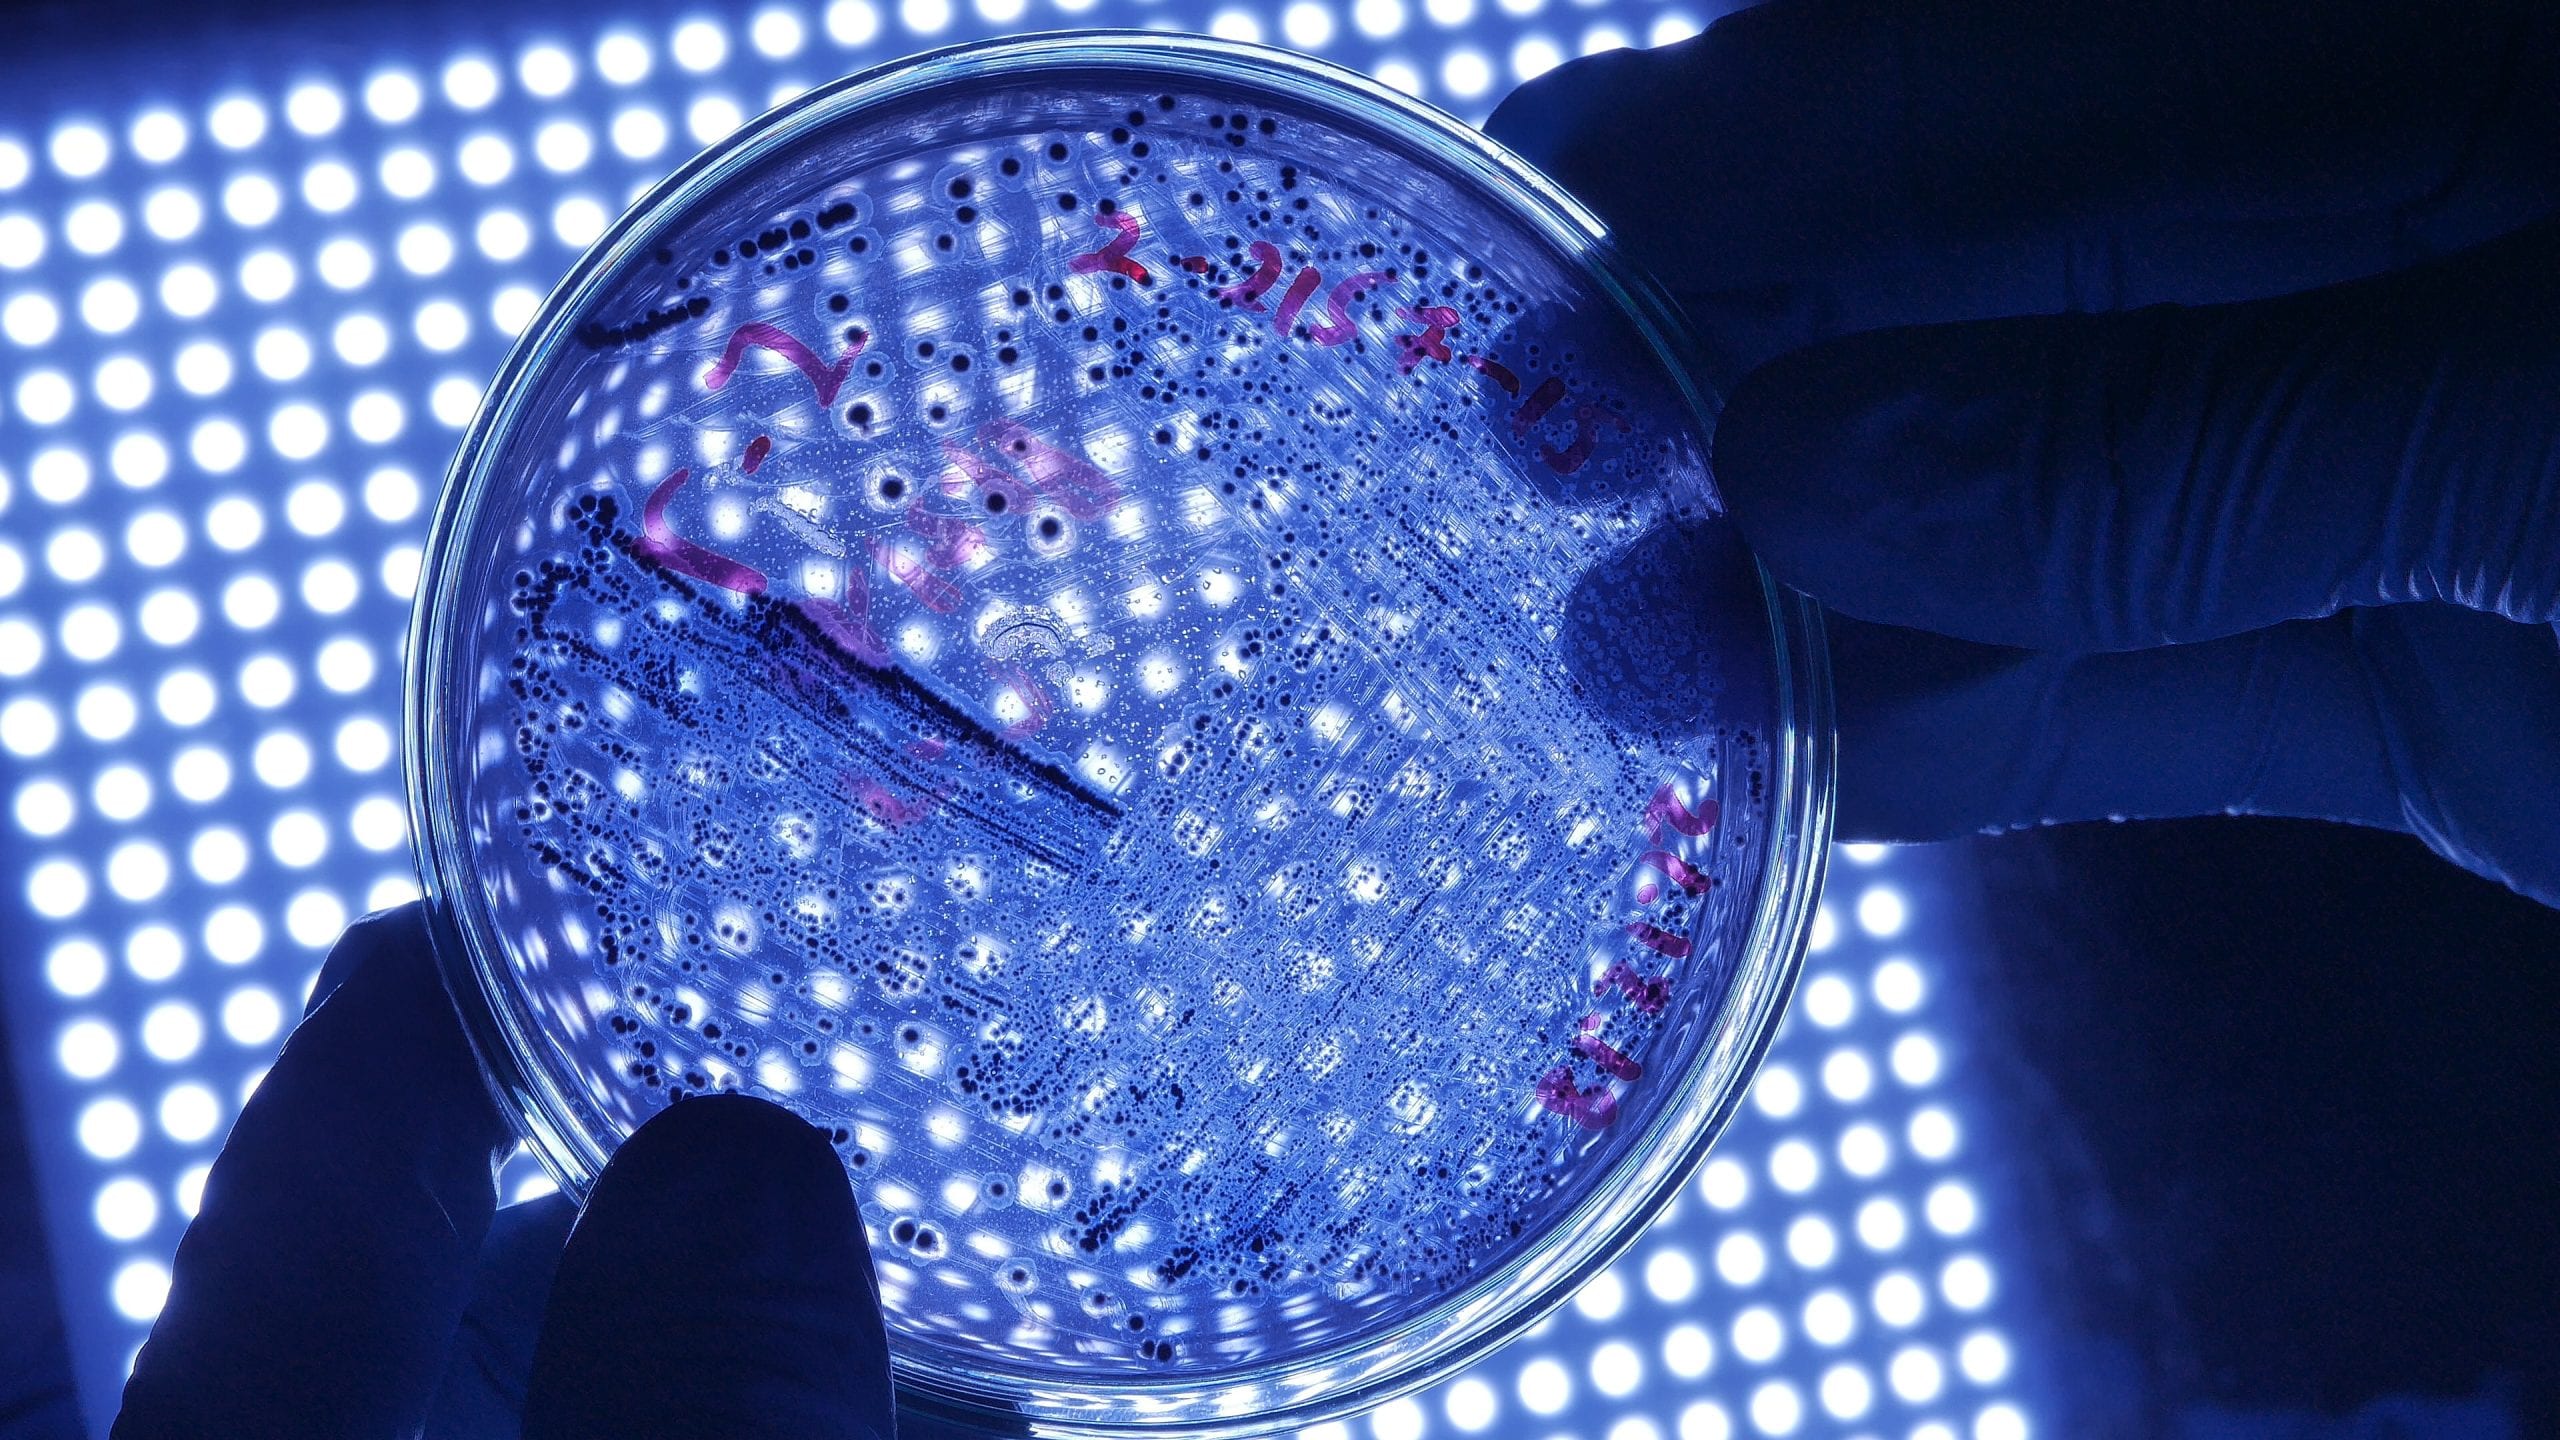

| 仪器 | 100V | 110V | 220V |
|---|---|---|---|
| 电压 | 100-120VAC | 100-120VAC | 220-240VAC |
| 频率 | 50/60 Hz | 60 Hz | 50/60 Hz |
| 功率 | 516W | 516W | 516W |
| 尺寸 | |||
| 长x宽x高:30.5 X 23 X 33 cm | |||
| 重量 | 千克 | ||
| 110V和220V系统 | |||
| 净重: | 15.0 | ||
| 运输重量: | 18.1 | ||
| 100V系统 | |||
| 净重: | 16.3 | ||
| 温度和湿度 | |||
| 运行条件 | 10°C 到 32°C,50°F 到 91°F | ||
| 相对湿度 | 20-80%相对湿度(不冷凝) | ||
| 存储条件 | 0°C 到 70°C,32°F 到 158°F | ||
| 支持的语言 | |||
| 西班牙语、德语、荷兰语、法语、简体中文、日语、韩语、俄语 | |||
| 资质证书 | |||
| 安装级别:I | |||
| 过电压等级:II | |||
| 净化级别:2 | |||
| 防潮:IPXO(普通) | |||
| 保修 | |||
| 一年的有限保修服务,包含所有部件,除玻璃,塑料和由其制造商保证的零件。 | |||
| 电压和频率 | 120V | 240V |
|---|---|---|
| 电压 | 90-126.5 VAC | 198-264 VAC |
| 频率 | 50/60 Hz | 50/60 Hz |